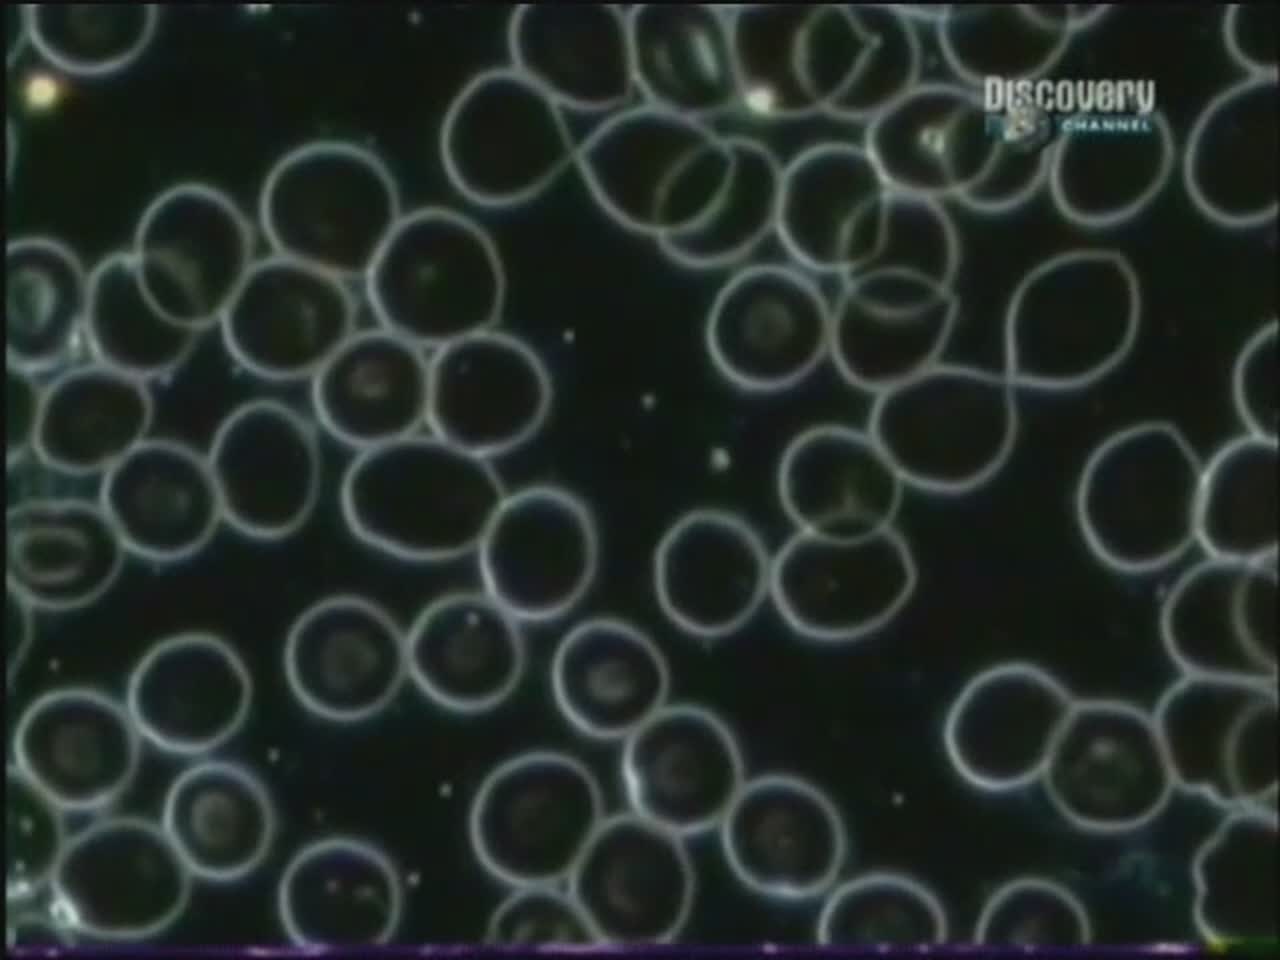

О сексе / Sex Sense
1999
Док. сериал
22 мин / серия
Документальные фильмы Discovery Channel, освещающие различные аспекты человеческой сексуальности.
Жанр
Страна
Сезоны и серии

1 серия
10 самых сексуальных предметов одежды

2 серия
Афродизиаки

3 серия
Безбрачие

4 серия
Бисексуальность

5 серия
Гомосексуальность

6 серия
Грудь

7 серия
Грязные Шутки

8 серия
Девичья сила

9 серия
Его сексуальное преображение

10 серия
Его сексуальное преображение

11 серия
Ее сексуальное преображение

12 серия
Её сексуальное преображение

13 серия
Женский Организм (Откровенный женский разговор)

14 серия
Женский Организм (Откровенный женский разговор)

15 серия
Жидкая любовь

16 серия
За пределами Моногамии

17 серия
Измена
18 серия
Лучший секс

19 серия
Менопауза

20 серия
Мифы о сексе

21 серия
Наиболее извращенный секс

22 серия
Не надо секса пожалуйста

23 серия
Нижняя черта (почему ягодицы считают сексуальными)

24 серия
Обнажить всё

25 серия
Обрезание

26 серия
Оргазм

27 серия
Первое Свидание

28 серия
Половое созревание

29 серия
Половой Акт

30 серия
Порнография

31 серия
Поцелуй

32 серия
Причины двуполости

33 серия
Процесс создания сериала

34 серия
Путешествие в мир фантазий

35 серия
Резинка Любви

36 серия
Самые сексуальные Предметы

37 серия
Свадьба

38 серия
Секс будущего

39 серия
Секс во время беременности

40 серия
Секс и Инвалидность

41 серия
Секс и культура

42 серия
Секс и спорт

43 серия
Секс против любви

44 серия
Сексуальная Зависимость

45 серия
Сексуальная Опытность

46 серия
Сексуальная Терапия

47 серия
Сексуальные Игрушки

48 серия
Сексуальные сигналы

49 серия
Сексуальные циклы

50 серия
Солнце, Песок и Секс

51 серия
Социальная Реконструкция

52 серия
Стриптиз

53 серия
Удовольствие и боль

54 серия
Фетишизм

55 серия
Фильмы для взрослых

56 серия
Чтобы всё получилось

57 серия
Что такое сексуальность

58 серия
Эксцентричный секс

59 серия
Яички

60 серия
Ящик